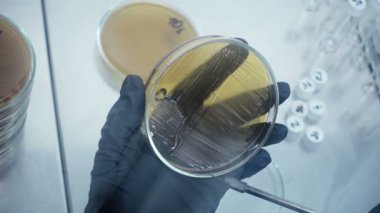
Bir örnek seçimi close-up. Mikrobiyolojik laboratuvar çalışma. Labortory, gerçek eser.

İhlal Bildirim Formu
En Çok Aranan Kelimeler
KırmızıRenklerArkaplanRenderGrafikselresimlemedizaynşekilGüzelYENİsanatSıvıSoyutTuruncuIşıkDoğalDesensiyahDalgamodernmanzarayaratıcıakışKavramHareketyumuşaksıcaktaşınıyorDijitalparlaTemizDinamikBasitkapakDuvar KağıdımalzemeeğilimgerçekçiVideoanimasyonvolkanerimelavMagmaerimişgrafik tasarımhareketli grafiklerUltra yüksek çözünürlüklülush lavaBenzer İçerikler